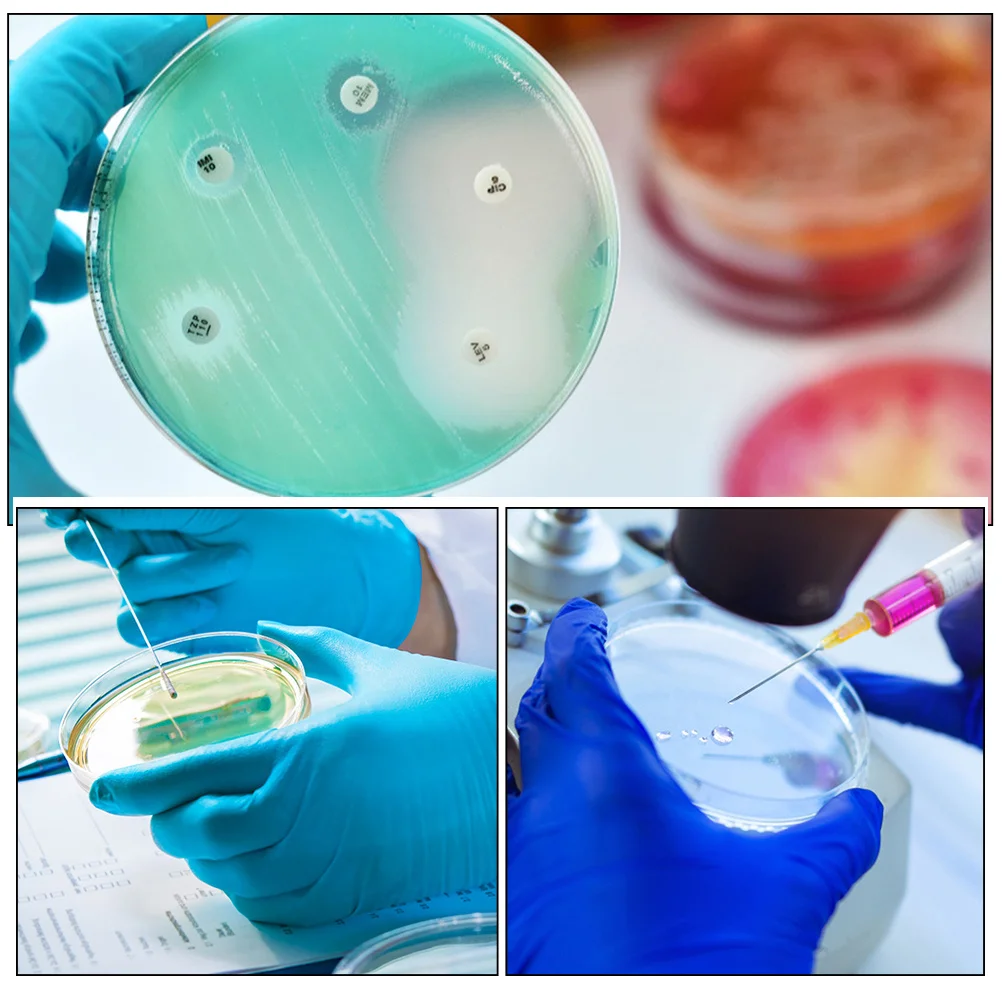

Большие термо-сумки для ланча, Термальный Ланч-бокс для женщин, простая стильная сумка для еды, сумка для пикника, сумка-холодильник, изолиро...














артикул: 1005005135548993
СОГЛАСНО НАШИМ ДАННЫМ, ЭТОТ ПРОДУКТ СЕЙЧАС НЕ ДОСТУПЕН
$21.59
Доставка из: Китай
График изменения цены & курс обмена валют
Пользователи также просматривали

$12.29
Phone Universal Heating-free LCD Screen Separator Adjustable Screen Disassembly Tool For Phone Repair Screen Splitter Tool
aliexpress.com
$10.93
Rory Gallagher T-Shirt designer shirts animal prinfor boys summer clothes t shirts men
aliexpress.com
$52.99
Модные летние новые сандалии для походов на открытом воздухе, мужская обувь, кожаные дышащие сандалии, нескользящие, плоские, с мягкой подошвой, дизайнерские сандалии ручной работы для мужчин 38 чёрный
joom.ru
$67.44
New Genuine Rear Oxygen Sensor OEM 22690AA940 For Subaru Impreza Legacy Forester 2009-2014
aliexpress.com
$10.92
5-полосный пренер LC5 звукосниматель акустической гитары предусилитель EQ ЖК-тюнер пьезоэквалайзер
aliexpress.com
$12.25
Autumn And Winter Fashion New Women's Elegant V-Neck Printed Top Loose Plus Size Temperament Casual Pullover
aliexpress.com
$4.91
Винтовой переходник с внутренней резьбой 1/4 дюйма на внутреннюю резьбу 3/8 дюйма, 3 шт.
aliexpress.com
$26.98
school Backpack Orthopedic kids bag Children School Bags For Girls boys Schoolbag book bag cartable Backpacks mochila sac a dos
aliexpress.com
$29.79
C24 2.4G DIY RC Car KIT Remote Control Car RC Crawler Off-Road Car Buggy Moving Machine RC Car 4WD Kids Toys Sales Promotion
aliexpress.com
$17.26
4PCs MATEK 2812 LED Strip Drone Frame Arm Board Night Light w/ 8 Lamps for RC FPV Racing f3 f4 f8 Flight Control
aliexpress.com$5.99
FunnyTech®Silicone Case for Samsung Galaxy S9 Plus L Texture pink marble combined
aliexpress.com
$4.48
Original silicone cases for Samsung S9 S9 plus case shockproof for Samsung Galaxy S9+ case luxury silicon cases with logo with retail box
dhgate.com
$1.83
10Pcs Plastic Petri Dishes Tissue Culture Plates Laboratory Science Experiment Supplies Durable Heat Resistant
aliexpress.ru
$14.00
Head Light Lamp Window Lift Button Electronic Handbrake Cover Trim Fit For Hyundai Palisade 2020 2021 2022 2023 Car Accessories
aliexpress.com
$167.01
DIY Full Color Tattoo Inkjet Printer Mini Mouse Printer Notebook Inkjet Printer for Office use
aliexpress.com
$16.56
Креативная коробка для мыла с лимоном, сливная полка для хранения мыла без накопления воды в ванной комнате, новая керамическая мыльница, аксессуары для ванной комнаты
aliexpress.ru
$20.10
Shanhaijing SA Лежащий ангел, деревянная палочка, толпа, играющая в глухая коробка, периферийное украшение для экрана, фигурка
aliexpress.ru
$23.54
Коврик в багажник автомобиля WYM для Lincoln MKX 2015 2016 2017 2018, автомобильные аксессуары на заказ, украшение интерьера автомобиля
aliexpress.ru
$14.18
Автомобильная сетка для средних насекомых, вставная сетка для передней решетки, защита от комаров и пыли для Honda INSPIRE 2019, аксессуары
aliexpress.ru
$17.85
Женский комплект домашней одежды больших размеров ort Sve круглые брюки Ne Spwear с принтом в виде сердца Удобная дышащая спортивная одежда
aliexpress.ru
$10.73
Новый черно-белый женский платок во французском стиле с буквами, большой квадратный шарф, саржевый шелковый платок, шарф, оптовая продажа
aliexpress.ru
$3.49
Автомобильная пленка, высокая яркость, темно-желтая автомобильная наклейка, виниловая пленка, ПЭТ, авто наклейка, без пузырьков, автомобильные аксессуары, украшение
aliexpress.ru
$6.32
A30F-276-6793 Датчик давления масла Датчик давления впускного давления Автозапчасти 2766793
aliexpress.ru
$2.34
Мотоциклетный топливный шланг, набор бензиновых фильтров с зажимами, газовая, устойчивая к коррозии, универсальная для мотоцикла, скутера, квадроцикла
aliexpress.ru
$32.91
Аутентичная виниловая сумка на молнии с изображением ребенка Three Maneki Neko, глухая коробка, очаровательные фигурки для сумки, подарок с красивым значением
aliexpress.ru






